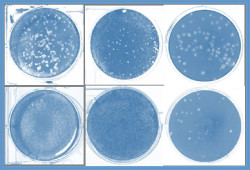
Investigadores del CSIC descubren que mol&eacute;culas sint&eacute;ticas de ARN inducen una respuesta inmune para el Covid-19

El mundo perdió 337 millones de años de vida en 2020 y 2021 por la pandemia de COVID-19, según la OMS
El mundo perdió 337 millones de años de vida durante 2020 y 2021 por la pandemia de COVID-19, según recoge el informe de Estadísticas Sanitarias Mundiales 2023, publicado este viernes por la Organización Mundial de la Salud (OMS).